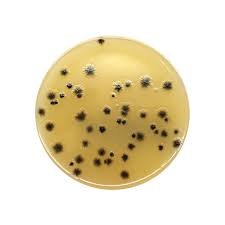

Buy Kanamycin Aesculin Azide (KAA) Agar 500m online for reliable microbial detection in food testing. High quality media for accurate results.
Kanamycin Aesculin Azide (KAA) Agar 500g
Introducing our high-quality Kanamycin Aesculin Azide (KAA) Agar, supplied in a convenient 500g pack. This specialized agar is designed for the selective isolation and enumeration of enterococci in water samples, making it an essential tool for water quality testing labs.
Features:
- Contains Kanamycin and Aesculin for selective isolation
- Includes Azide for inhibition of gram-negative bacteria
- 500g pack size for multiple applications
Our Kanamycin Aesculin Azide (KAA) Agar is manufactured to the highest standards to ensure accurate and reliable results. The unique formulation of this agar allows for the specific growth of enterococci bacteria while suppressing the growth of unwanted organisms.
Applications:
- Water quality testing
- Environmental microbiology
- Research and development
Order your Kanamycin Aesculin Azide (KAA) Agar today and experience the benefits of this specialized agar for your microbiology applications. Trust our high-quality products for all your laboratory needs!